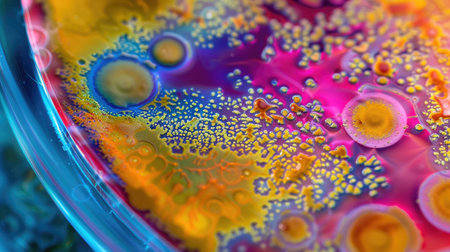
A petri dish teeming with a colorful array of bacterial growth, showing the beauty of microbiology.の素材

素材 - A petri dish teeming with a colorful array of bacterial growth, showing the beauty of microbiology.
作品情報
A petri dish teeming with a colorful array of bacterial growth, showing the beauty of microbiology.
- ID:226146773
- 作品種別:
- 作者名:veiksme
キーワード
- agar
- agarose
- analysis
- bacteria
- biochemistry
- biofilms
- biological
- biotechnology
- cells
- cellular
- clinical
- close-up
- colonies
- colony
- colorful
- contamination
- cultures
- development
- diagnostic
- diverse
- diversity
- experimentation
- fluoresce
- genetics
- growth
- health
- incubation
- infectious
- lab
- laboratory
- medicine
- microbe
- microbiology
- microorganisms
- microscopic
- morphology
- nutrient
- observation
- organism
- pathogens
- petri dish
- plates
- research
- samples
- scientific
- staining
- sterile
- study
- vibrant
類似作品
array of cookin...
A visually stun...
Chef plating a ...
Classical Turki...
Colorful tradit...
Colorful plates...
Turkish handmad...
A chef garnishi...
A dining scene ...
A lot of multi-...
Modern and vibr...
A colorful plat...
A vibrant and a...
A hand sprinkli...
Fresh cut veget...
Colorful candie...
Different ceram...
Clean moroccan ...
A large variety...
A vibrant bowl ...
Overhead view o...
High cuisine. M...
A plate featuri...
Beet and carrot...
Traditional Tur...
A plate of food...
Colored dinnerw...
close-up of dis...
High-angle view...
Lot of whole sw...
A chef tossing ...
Nam Prik Num (N...
A vibrant shot ...
Close-up of a b...
3d render of ab...
Variety of colo...
hands preparing...
Landscape photo...
A breathtaking ...
A portion of sa...
Chef cooking a ...
Woman enjoying ...
A mouthwatering...
many colorful k...
Colorful food w...
Escabeche fish ...
Chef Arranging ...
Dirty plates fi...
Cut fruits stan...